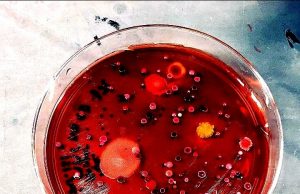
One quarter of bacterial pathogens can spread antibiotic resistance directly to peers One quarter of bacterial pathogens can spread antibiotic resistance directly to peers

Karina
Machine learning technique speeds up crystal structure determination
Nanoengineers at the University of California San Diego have developed a computer-based method that could make it less labor-intensive to determine the crystal structures...
Researchers make critical advances in quantifying methane released from the Arctic...
A new study, lead by researchers at Stockholm University and published in Science Advances, now demonstrate that the amount of methane presently leaking into the...
The role of temporal fluctuations for the swing feel in jazz...
In 1931, Duke Ellington and Irving Mills dedicated a song to the phenomenon of swing, which they called "It Don't Mean a Thing, If...
Modern Africans and Europeans may have more Neanderthal ancestry than previously...
Neanderthal DNA sequences may be more common in modern Africans than previously thought, and different non-African populations have levels of Neanderthal ancestry surprisingly similar...
Oysters as catch of the day? Perhaps not, if ocean acidity...
When it comes to carbon emissions, people tend to focus more on what happens in the atmosphere and on land. But about a quarter...
Meteorites reveal high carbon dioxide levels on early Earth
Tiny meteorites no larger than grains of sand hold new clues about the atmosphere on ancient Earth, according to scientists.
Iron micrometeorites found in ancient...
Cheap nanoparticles stimulate immune response to cancer in the lab
University of Wisconsin-Madison researchers have developed nanoparticles that, in the lab, can activate immune responses to cancer cells. If they are shown to work...
One quarter of bacterial pathogens can spread antibiotic resistance directly to...
Biomedical engineers at Duke University have demonstrated that at least 25 percent of antibiotic-resistant pathogenic bacteria found in clinical settings are capable of spreading...
Coupled quantum dots may offer a new way to store quantum...
Researchers at the National Institute of Standards and Technology (NIST) and their colleagues have for the first time created and imaged a novel pair...
Scientists develop a concept of a hybrid thorium reactor
Russian scientists have proposed a concept of a thorium hybrid reactor in that obtains additional neutrons using high-temperature plasma held in a long magnetic...
Scientists learn how plants manipulate their soil environment to assure a...
The next time you're thinking about whether to cook dinner or order a pizza for delivery, think of this: Plants have been doing pretty...